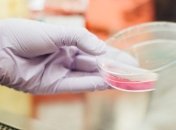
Все через Prozorro: Украина закупила около 15 тыс. тестов на коронавирус

Новости по теме Заболевание
-

В связи с распространением коронавируса в Италии медики зарегистрировали уже более 10 000 случаев смерти от пневмонии.
-

В связи с распространением коронавируса в мире врачи в Нидерландах зарегистрировали более 1100 случаев инфицирования.
-

В связи с распространением коронавируса в США одна из газет Нью-Йорка прокомментировала ситуацию в городе.
-

Ученые проливают свет на тяжелое воспалительное заболевание желудка и кишечника и называют факторы, на которые можно воздействовать в профилактических целях.
-

В Украине в связи с распространением коронавируса в Черновицкой области планируют усилить карантинные меры.
-

В связи с распространением коронавируса в Украине и созданием спецучреждений в них будет организовано питание и комнаты отдыха для персонала.
-
В сявзи с распространением коронавируса в Украине организовали закупки более 14 000 тестов на определение болезни.
-

В связи с распространением коронавируса в Украине депутаты Николаевского облсовета выделили более 100 миллионов на борьбу с вирусом.
-

В связи с распространением коронавируса в мире медики в Британии зарегистрировали уже более 1000 случаев смерти от вируса.
-

В результате принятия новых правок в законопроект о рынке земли, время старта будет отсрочено и будет органичена его работа в первые два года.
-

В связи с распространением коронавируса в Украине медики зафискировали уже 59 случаев заражения в Черновицкой области.
-

В связи с распространением коронавируса в Украине и введением ЧС на Херсонщине на самоизоляции находятся более 890 человек.
-

В связи с распространением коронавируса в РФ медики зарегисировали уже более 1200 случаев заражения среди населения.
-

В связи с распространением к оронавируса в Испании медики зафиксировали уже более 830 случаев смерти от заболевания за прошедшие сутки.
-

В связи с распространением коронавируса в Украине в Минздраве поддерживают возобновление собственного производства аппаратов ИВЛ.
-

В связи с распространением коронавируса в Латвии медики зафиксировали уже более 300 случаев заболевания.

